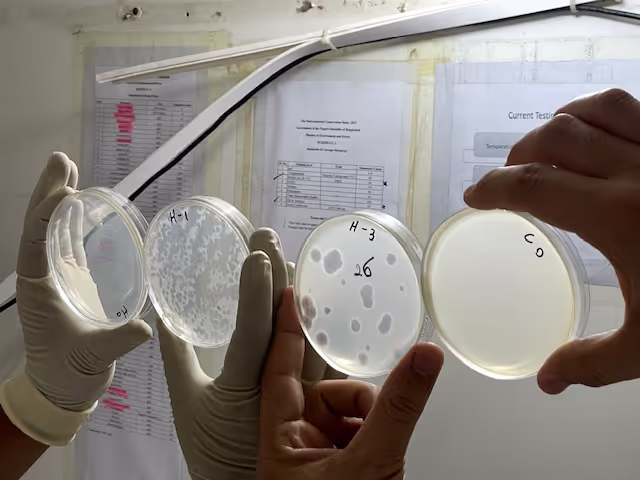

Gender-based violence (GBV)
Addressing gender-based violence and improving access to services and support and outcomes for survivors.
Discover how Elrha supports and funds grantees to drive impactful research and innovation in humanitarian work. Learn more about our funding opportunities and how we help bring transformative ideas to life.
%20-%2042%20of%2083%20(1).jpg)